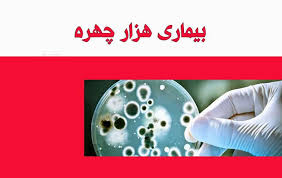

بیماری هزار چهرهای که همه افراد را تحت تأثیر قرار میدهد
یک متخصص باکتریشناس از بروسلوز به عنوان بیماری نام برد که همه افراد را در هر سن و هر جنسی تحت تأثیر قرار میدهد.
شفاآنلاین> سلامت> سجاد یعقوبی افزود: بروسلوز یک نوع بیماری باکتریایی است که توسط گونههای مختلف بروسلا ایجاد میشود و عمدتاً گاو، خوک، بز، گوسفند و سگ را مبتلا میکند.
شفاآنلاین> سلامت> سجاد یعقوبی افزود: بروسلوز یک نوع بیماری باکتریایی است که توسط گونههای مختلف بروسلا ایجاد میشود و عمدتاً گاو، خوک، بز، گوسفند و سگ را مبتلا میکند. به گزارش شفاآنلاین: وی اظهار کرد: انسانها از طریق تماس مستقیم با حیوانات آلوده، خوردن یا نوشیدن محصولات حیوانی آلوده یا استنشاق عوامل موجود در هوا به این بیماری مبتلا میشوند.
این متخصص باکتریشناس بیان کرد: بیماری بروسلوز معمولاً علائمی شبیه آنفلوآنزا از جمله تب، ضعف و کاهش وزن ایجاد میکند اما ممکن است در اشکال غیر معمول و با علائم خفیف ظاهر شود که منجر به عدم تشخیص این بیماری شود.
وی با بیان اینکه بیشتر موارد ابتلا، ناشی از مصرف شیر یا پنیر غیر پاستوریزه از بز یا گوسفند آلوده است، در خصوص اینکه چه کسانی در معرض خطر هستند؟ گفت: تحقیقات نشان داده این بیماری افراد در هر سن و هر جنسی را تحت تأثیر قرار میدهد.
یعقوبی بیان کرد: بیماری بروسلوز یک خطر شغلی برای افرادی که در بخش دامداری کار میکنند یا افرادی که با خون، جفت، جنین و ترشحات رحمی حیوانات در تماس هستند، محسوب میشود.
وی خطر ابتلا به این بیماری را در این افراد افزایشی دانست و تصریح کرد: در جمعیت عمومی، بیشتر موارد ناشی از مصرف شیر خام یا مشتقات آن مانند پنیر تازه است. بیشتر این موارد از محصولات گوسفند و بز است.
این متخصص باکتریشناس با اشاره به اینکه این روش انتقال در درجه اول کشاورزان، قصابان، شکارچیان، دامپزشکان و پرسنل آزمایشگاهی را تحت تأثیر قرار میدهد، در خصوص راههای پیشگیری و کنترل گفت: پیشگیری از بیماری بروسلوز بر اساس مراقبت و پیشگیری از عوامل خطر است.
وی با بیان اینکه مؤثرترین راهبرد پیشگیری از بین بردن عفونت در حیوانات است، به واکسیناسیون گاو، بز و گوسفند در مناطقی با میزان شیوع بالا توصیه کرد و گفت: در مناطقی که ریشهکنی در حیوانات از طریق واکسیناسیون یا حذف حیوانات آلوده امکانپذیر نباشد، پیشگیری از عفونت انسان، اساساً مبتنی بر افزایش آگاهی، اقدامات ایمنی غذایی، بهداشت شغلی و ایمنی آزمایشگاهی است./ایسنا
نظرات بینندگان

آخرین اخبار
